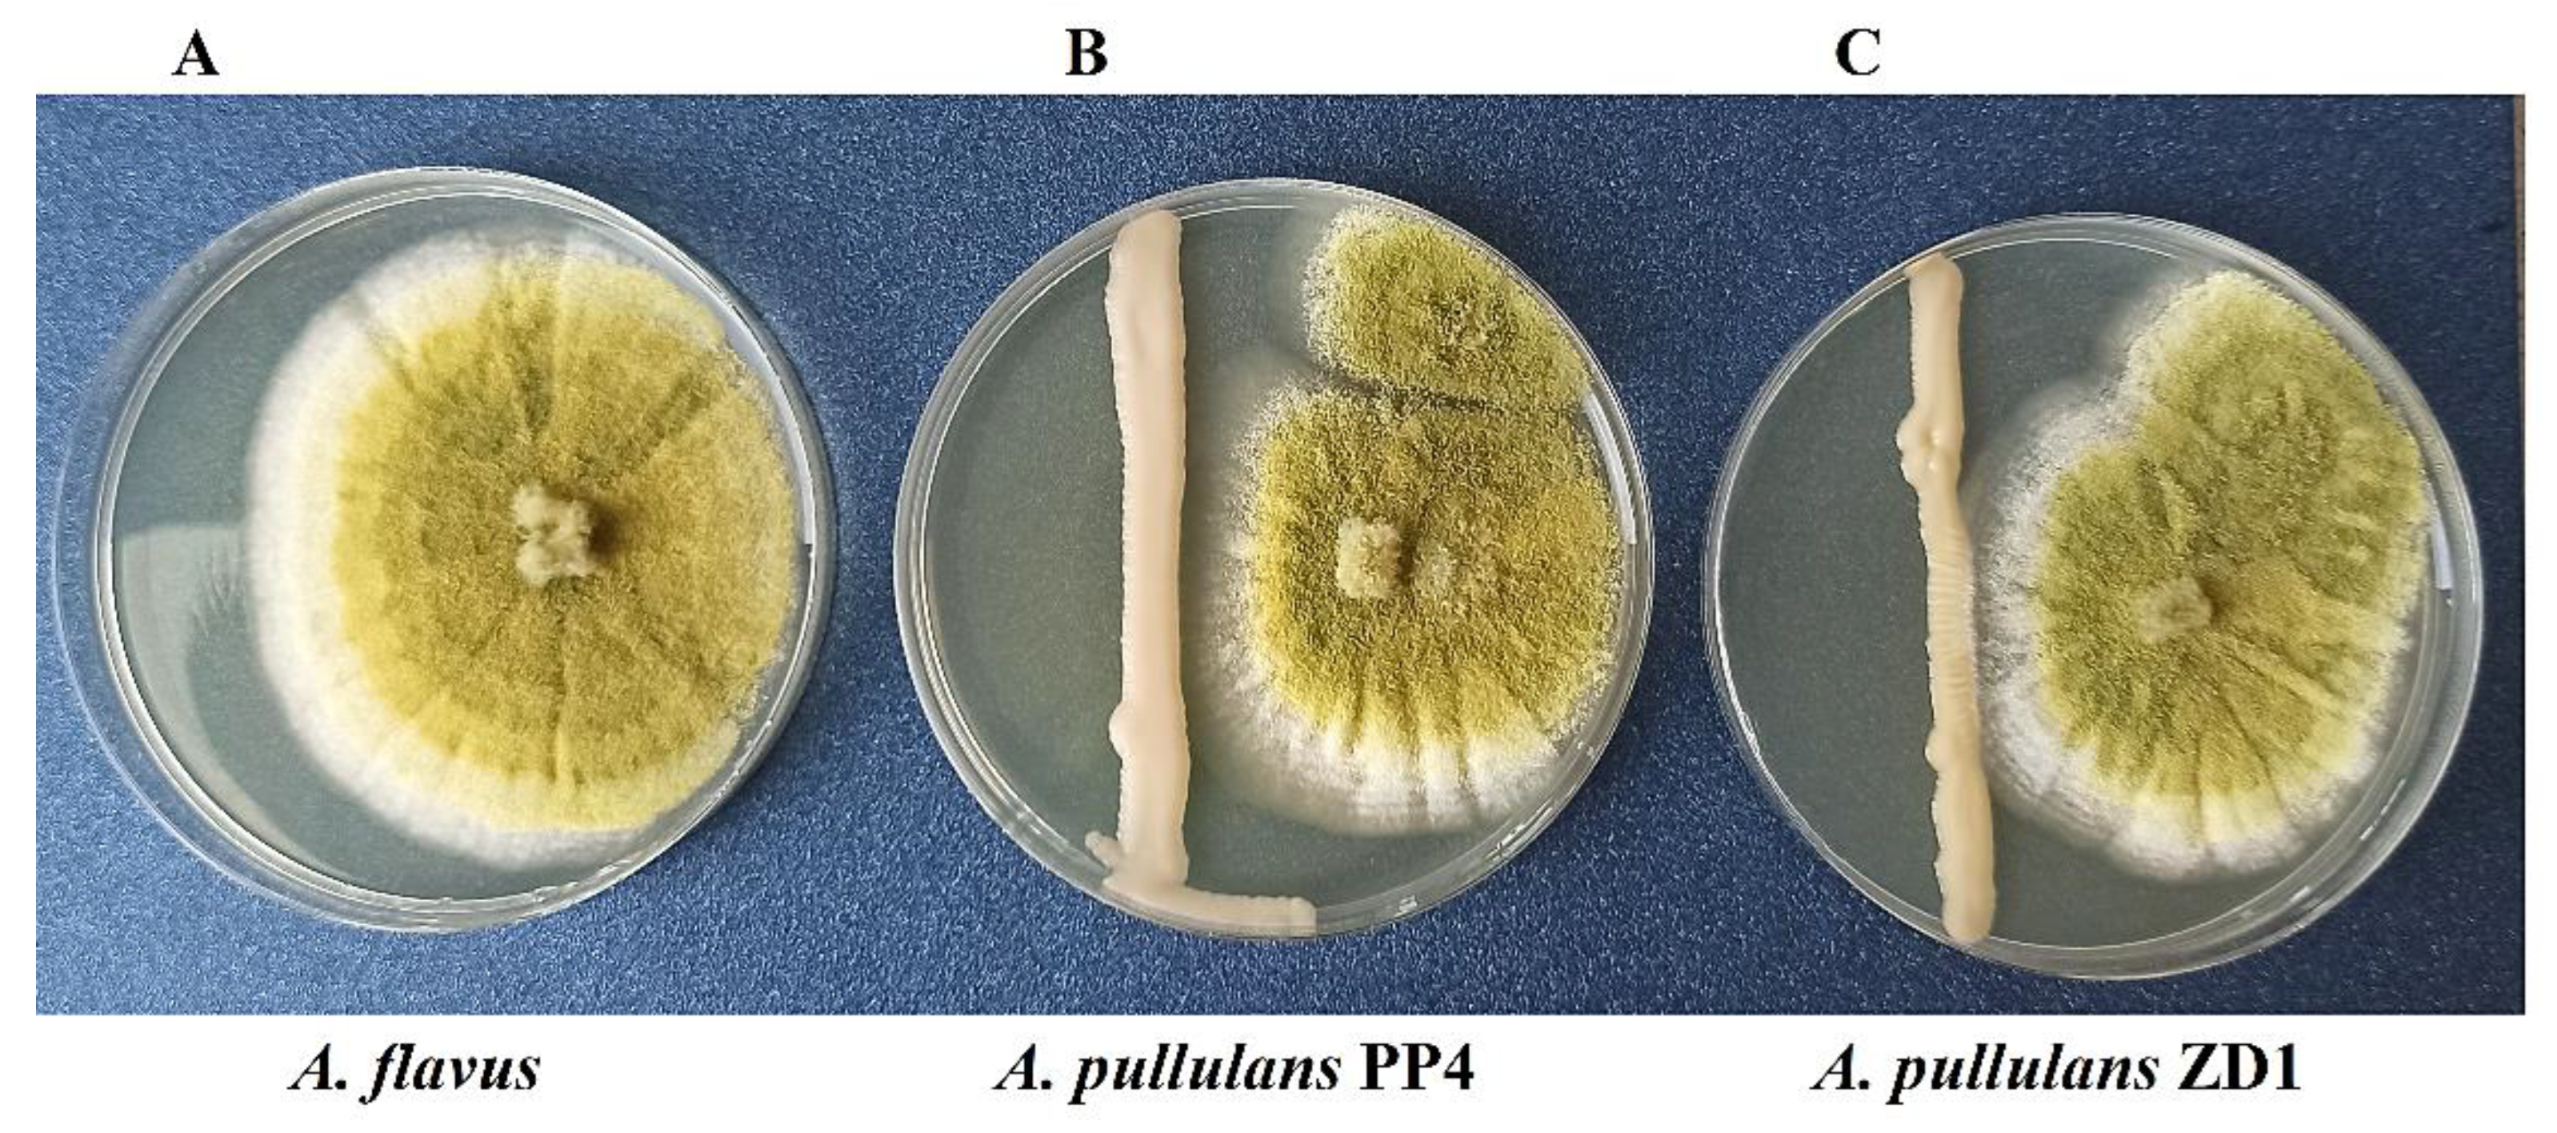
Plants 12 00236 g001

Biological Control of Aspergillus flavus by the Yeast Aureobasidium pullulans In Vitro and on Tomato Fruit
Abstract
1. Introduction
2. Results
2.1. Confrontation Assay
2.2. Effect on A. flavus Spore Germination In Vitro
2.3. Enzymatic Activities
2.4. The Capacity of Yeast to Survive under Harsh Environmental Conditions
2.5. Effect of Fungicides on Tested Microorganisms In Vitro
2.6. Biocontrol of A. flavus by Yeast in Tomato Fruit
3. Discussion
4. Materials and Methods
4.1. Microorganisms
4.2. Confrontation Assay
4.3. Effect on A. flavus Spore Germination In Vitro
4.4. Enzymatic Activities
4.5. The Capacity of Yeasts to Survive under Harsh Environmental Conditions
4.6. Effect of Fungicides on Tested Yeast In Vitro
4.7. Biocontrol of A. flavus by Yeast in Tomato Fruit
4.8. Statistical Analysis
5. Conclusions
Funding
Data Availability Statement
Conflicts of Interest
References
- Daou, R.; Joubrane, K.; Maroun, R.G.; Khabbaz, L.R.; Ismail, A.; El Khoury, A.; Daou, R.; Joubrane, K.; Maroun, R.G.; Khabbaz, L.R.; et al. Mycotoxins: Factors Influencing Production and Control Strategies. AIMS Agric. Food 2021, 6, 416–447. [Google Scholar] [CrossRef]
- Faria, C.B.; dos Santos, F.C.; de Castro, F.F.; Sutil, A.R.; Sergio, L.M.; Silva, M.V.; Machinski, M.; Barbosa-Tessmann, I.P. Occurrence of Toxigenic Aspergillus flavus in Commercial Bulgur Wheat. Food Sci. Technol. 2017, 37, 103–111. [Google Scholar] [CrossRef]
- Segura-Palacios, M.A.; Correa-Pacheco, Z.N.; Corona-Rangel, M.L.; Martinez-Ramirez, O.C.; Salazar-Piña, D.A.; Ramos-García, M.D.L.; Bautista-Baños, S. Use of Natural Products on the Control of Aspergillus flavus and Production of Aflatoxins in Vitro and on Tomato Fruit. Plants 2021, 10, 2553. [Google Scholar] [CrossRef] [PubMed]
- Kumar, A.; Pathak, H.; Bhadauria, S.; Sudan, J. Aflatoxin Contamination in Food Crops: Causes, Detection, and Management: A Review. Food Prod. Process. Nutr. 2021, 3, 17. [Google Scholar] [CrossRef]
- Douksouna, Y.; Masanga, J.; Nyerere, A.; Runo, S.; Ambang, Z. Towards Managing and Controlling Aflatoxin Producers within Aspergillus Species in Infested Rice Grains Collected from Local Markets in Kenya. Toxins 2019, 11, 544. [Google Scholar] [CrossRef]
- Saleem, A.R. Mycobiota and Molecular Detection of Aspergillus flavus and A. parasiticus Aflatoxin Contamination of Strawberry (Fragaria ananassa Duch.) Fruits. Arch. Phytopathol. Plant Prot. 2017, 50, 982–996. [Google Scholar] [CrossRef]
- Ghuffar, S.; Irshad, G.; Ahmed, M.Z.; Zeshan, M.A.; Ali, R.; Haq, E.; Anwaar, A.; Abdullah, A.; Ahmad, F. First Report Of Aspergillus flavus Causing Fruit Rot of Grapes (Vitis vinifera) in Pakistan. Plant Dis. 2020, 104, 3062. [Google Scholar] [CrossRef]
- De Souza, E.L.; Sales, C.V.; de Oliveira, C.E.V.; Lopes, L.A.A.; da Conceição, M.L.; Berger, L.R.R.; Stamford, T.C.M. Efficacy of a Coating Composed of Chitosan from Mucor circinelloides and Carvacrol to Control Aspergillus flavus and the Quality of Cherry Tomato Fruits. Front. Microbiol. 2015, 6, 732. [Google Scholar] [CrossRef][Green Version]
- Sopialena, S.; Subiono, T.; Rosyidin, A.U.; Tantiani, D. Control of Antracnose Disease in Tomato (Solanum lycopersicum) Using Endophytic Fungi. KnE Life Sci. 2022, 2022, 393–408. [Google Scholar] [CrossRef]
- Pandey, A.K.; Kumar, A.; Dinesh, K.; Varshney, R.; Dutta, P. The Hunt for Beneficial Fungi for Tomato Crop Improvement—Advantages and Perspectives. Plant Stress 2022, 6, 100110. [Google Scholar] [CrossRef]
- Malik, M.S.; Haider, S.; Rehman, A.; Rehman, S.U.; Jamil, M.; Naz, I.; Anees, M. Biological Control of Fungal Pathogens of Tomato (Lycopersicon esculentum) by Chitinolytic Bacterial Strains. J. Basic Microbiol. 2022, 62, 48–62. [Google Scholar] [CrossRef] [PubMed]
- Freimoser, F.M.; Rueda-Mejia, M.P.; Tilocca, B.; Migheli, Q. Biocontrol Yeasts: Mechanisms and Applications. World J. Microbiol. Biotechnol. 2019, 35, 154. [Google Scholar] [CrossRef] [PubMed]
- Konsue, W.; Dethoup, T.; Limtong, S. Biological Control of Fruit Rot and Anthracnose of Postharvest Mango by Antagonistic Yeasts from Economic Crops Leaves. Microorganisms 2020, 8, 317. [Google Scholar] [CrossRef] [PubMed]
- Bozoudi, D.; Tsaltas, D. The Multiple and Versatile Roles of Aureobasidium pullulans in the Vitivinicultural Sector. Fermentation 2018, 4, 85. [Google Scholar] [CrossRef]
- Yalage Don, S.M.; Schmidtke, L.M.; Gambetta, J.M.; Steel, C.C. Aureobasidium pullulans Volatilome Identified by a Novel, Quantitative Approach Employing SPME-GC-MS, Suppressed Botrytis cinerea and Alternaria alternata in Vitro. Sci. Rep. 2020, 10, 4498. [Google Scholar] [CrossRef]
- Agirman, B.; Erten, H. Biocontrol Ability and Action Mechanisms of Aureobasidium pullulans GE17 and Meyerozyma guilliermondii KL3 against Penicillium digitatum DSM2750 and Penicillium expansum DSM62841 Causing Postharvest Diseases. Yeast 2020, 37, 437–448. [Google Scholar] [CrossRef]
- Di Francesco, A.; Di Foggia, M.; Corbetta, M.; Baldo, D.; Ratti, C.; Baraldi, E. Biocontrol Activity and Plant Growth Promotion Exerted by Aureobasidium pullulans Strains. J. Plant Growth Regul. 2021, 40, 1233–1244. [Google Scholar] [CrossRef]
- Di Francesco, A.; Ugolini, L.; D’Aquino, S.; Pagnotta, E.; Mari, M. Biocontrol of Monilinia laxa by Aureobasidium pullulans Strains: Insights on Competition for Nutrients and Space. Int. J. Food Microbiol. 2017, 248, 32–38. [Google Scholar] [CrossRef]
- Pobiega, K.; Przybył, J.L.; Żubernik, J.; Gniewosz, M. Prolonging the Shelf Life of Cherry Tomatoes by Pullulan Coating with Ethanol Extract of Propolis During Refrigerated Storage. Food Bioprocess Technol. 2020, 13, 1447–1461. [Google Scholar] [CrossRef]
- Magoye, E.; Hilber-Bodmer, M.; Pfister, M.; Freimoser, F.M. Unconventional Yeasts Are Tolerant to Common Antifungals, and Aureobasidium pullulans Has Low Baseline Sensitivity to Captan, Cyprodinil, and Difenoconazole. Antibiotics 2020, 9, 602. [Google Scholar] [CrossRef]
- Kowalska, J.; Krzymińska, J.; Tyburski, J. Yeasts as a Potential Biological Agent in Plant Disease Protection and Yield Improvement—A Short Review. Agriculture 2022, 12, 1404. [Google Scholar] [CrossRef]
- Bencheqroun, S.K.; Bajji, M.; Massart, S.; Labhilili, M.; El Jaafari, S.; Jijakli, M.H. In Vitro and in Situ Study of Postharvest Apple Blue Mold Biocontrol by Aureobasidium pullulans: Evidence for the Involvement of Competition for Nutrients. Postharvest Biol. Technol. 2007, 46, 128–135. [Google Scholar] [CrossRef]
- Zhang, D.; Spadaro, D.; Garibaldi, A.; Gullino, M.L. Efficacy of the Antagonist Aureobasidium pullulans PL5 against Postharvest Pathogens of Peach, Apple and Plum and Its Modes of Action. Biol. Control 2010, 54, 172–180. [Google Scholar] [CrossRef]
- Tejero, P.; Martín, A.; Rodríguez, A.; Galván, A.I.; Ruiz-Moyano, S.; Hernández, A. In Vitro Biological Control of Aspergillus flavus by Hanseniaspora opuntiae L479 and Hanseniaspora uvarum L793, Producers of Antifungal Volatile Organic Compounds. Toxins 2021, 13, 663. [Google Scholar] [CrossRef] [PubMed]
- Moradi, M.; Rohani, M.; Fani, S.R.; Mosavian, M.T.H.; Probst, C.; Khodaygan, P. Biocontrol Potential of Native Yeast Strains against Aspergillus flavus and Aflatoxin Production in Pistachio. Food Addit. Contam. Part A 2020, 37, 1963–1973. [Google Scholar] [CrossRef]
- Jaibangyang, S.; Nasanit, R.; Limtong, S. Biological Control of Aflatoxin-Producing Aspergillus flavus by Volatile Organic Compound-Producing Antagonistic Yeasts. BioControl 2020, 65, 377–386. [Google Scholar] [CrossRef]
- Abdel-Kareem, M.M.; Rasmey, A.M.; Zohri, A.A. The Action Mechanism and Biocontrol Potentiality of Novel Isolates of Saccharomyces cerevisiae against the Aflatoxigenic Aspergillus flavus. Lett. Appl. Microbiol. 2019, 68, 104–111. [Google Scholar] [CrossRef]
- Sukmawati, D.; Family, N.; Hidayat, I.; Sayyed, R.Z.; Elsayed, E.A.; Dailin, D.J.; Hanapi, S.Z.; Wadaan, M.A.; El Enshasy, H. Biocontrol Activity of Aureubasidium pullulans and Candida Orthopsilosis Isolated from Tectona grandis L. Phylloplane against Aspergillus sp. in Post-Harvested Citrus Fruit. Sustainability 2021, 13, 7479. [Google Scholar] [CrossRef]
- Fernandez-San Millan, A.; Larraya, L.; Farran, I.; Ancin, M.; Veramendi, J. Successful Biocontrol of Major Postharvest and Soil-Borne Plant Pathogenic Fungi by Antagonistic Yeasts. Biol. Control 2021, 160, 104683. [Google Scholar] [CrossRef]
- Hua, S.S.T.; Beck, J.J.; Sarreal, S.B.L.; Gee, W. The Major Volatile Compound 2-Phenylethanol from the Biocontrol Yeast, Pichia anomala, Inhibits Growth and Expression of Aflatoxin Biosynthetic Genes of Aspergillus flavus. Mycotoxin Res. 2014, 30, 71–78. [Google Scholar] [CrossRef]
- Banani, H.; Spadaro, D.; Zhang, D.; Matic, S.; Garibaldi, A.; Gullino, M.L. Biocontrol Activity of an Alkaline Serine Protease from Aureobasidium pullulans Expressed in Pichia pastoris against Four Postharvest Pathogens on Apple. Int. J. Food Microbiol. 2014, 182–183, 1–8. [Google Scholar] [CrossRef] [PubMed]
- Zhang, D.; Spadaro, D.; Valente, S.; Garibaldi, A.; Gullino, M.L. Cloning, Characterization, Expression and Antifungal Activity of an Alkaline Serine Protease of Aureobasidium pullulans PL5 Involved in the Biological Control of Postharvest Pathogens. Int. J. Food Microbiol. 2012, 153, 453–464. [Google Scholar] [CrossRef] [PubMed]
- Podgórska-Kryszczuk, I.; Solarska, E.; Kordowska-Wiater, M. Biological Control of Fusarium culmorum, Fusarium graminearum and Fusarium poae by Antagonistic Yeasts. Pathogens 2022, 11, 86. [Google Scholar] [CrossRef] [PubMed]
- Zajc, J.; Anja, Č.; Di Francesco, A.; Castoria, R.; De Curtis, F.; Badri, H.; Jijakli, H.; Ippolito, A.; GostinČar, C.; Zalar, P.; et al. Characterization of Aureobasidium Pullulans Isolates Selected as Biocontrol Agents against Fruit Decay Pathogens. Fungal Genom. Biol. 2020, 10, 1–13. [Google Scholar]
- Karlsson, I.; Friberg, H.; Steinberg, C.; Persson, P. Fungicide Effects on Fungal Community Composition in the Wheat Phyllosphere. PLoS ONE 2014, 9, e111786. [Google Scholar] [CrossRef] [PubMed]
- Pinto, C.; Custódio, V.; Nunes, M.; Songy, A.; Rabenoelina, F.; Courteaux, B.; Clément, C.; Gomes, A.C.; Fontaine, F. Understand the Potential Role of Aureobasidium pullulans, a Resident Microorganism from Grapevine, to Prevent the Infection Caused by Diplodia seriata. Front. Microbiol. 2018, 9, 3047. [Google Scholar] [CrossRef]
- Wang, D.; Yu, X.; Gongyuan, W. Pullulan Production and Physiological Characteristics of Aureobasidium Pullulans under Acid Stress. Appl. Microbiol. Biotechnol. 2013, 97, 8069–8077. [Google Scholar] [CrossRef] [PubMed]
- West, T.P. Production of the Polysaccharide Pullulan by Aureobasidium pullulans Cell Immobilization. Polysaccharides 2022, 3, 544–555. [Google Scholar] [CrossRef]
- Hohmann, S. Control of High Osmolarity Signalling in the Yeast Saccharomyces cerevisiae. FEBS Lett. 2009, 583, 4025–4029. [Google Scholar] [CrossRef]
- Dimakopoulou, M.; Tjamos, S.E.; Antoniou, P.P.; Pietri, A.; Battilani, P.; Avramidis, N.; Markakis, E.A.; Tjamos, E.C. Phyllosphere Grapevine Yeast Aureobasidium pullulans Reduces Aspergillus carbonarius (Sour Rot) Incidence in Wine-Producing Vineyards in Greece. Biol. Control 2008, 46, 158–165. [Google Scholar] [CrossRef]
- Vadkertiová, R.; Sláviková, E. Influence of Pesticides on Yeasts Colonizing Leaves. Z. Naturforsch. Sect. C J. Biosci. 2011, 66, 588–594. [Google Scholar] [CrossRef] [PubMed]
- Kucharska, K.; Wachowska, U.; Czaplicki, S. Wheat Phyllosphere Yeasts Degrade Propiconazole. BMC Microbiol. 2020, 20, 242. [Google Scholar] [CrossRef] [PubMed]
- Wachowska, U.; Irzykowski, W.; Jędryczka, M. Agrochemicals: Effect on Genetic Resistance in Yeasts Colonizing Winter Wheat Kernels. Ecotoxicol. Environ. Saf. 2018, 162, 77–84. [Google Scholar] [CrossRef] [PubMed]
- Hayes, B.M.E.; Anderson, M.A.; Traven, A.; Van Der Weerden, N.L.; Bleackley, M.R. Activation of Stress Signalling Pathways Enhances Tolerance of Fungi to Chemical Fungicides and Antifungal Proteins. Cell. Mol. Life Sci. 2014, 71, 2651–2666. [Google Scholar] [CrossRef]
- Janisiewicz, W.J.; Tworkoski, T.J.; Sharer, C. Characterizing the Mechanism of Biological Control of Postharvest Diseases on Fruits with a Simple Method to Study Competition for Nutrients. Phytopathology 2000, 90, 1196–1200. [Google Scholar] [CrossRef] [PubMed]
- Di Francesco, A.; Di Foggia, M.; Zajc, J.; Gunde-Cimerman, N.; Baraldi, E. Study of the Efficacy of Aureobasidium Strains Belonging to Three Different Species: A. pullulans, A. subglaciale and A. melanogenum against Botrytis cinerea of Tomato. Ann. Appl. Biol. 2020, 177, 266–275. [Google Scholar] [CrossRef]
- Shi, Y.; Yang, Q.; Zhao, Q.; Dhanasekaran, S.; Ahima, J.; Zhang, X.; Zhou, S.; Droby, S.; Zhang, H. Aureobasidium pullulans S-2 Reduced the Disease Incidence of Tomato by Influencing the Postharvest Microbiome during Storage. Postharvest Biol. Technol. 2022, 185, 111809. [Google Scholar] [CrossRef]
- Shi, Y.; Yang, Q.; Zhang, Q.; Zhao, Q.; Godana, E.A.; Zhang, X.; Zhou, S.; Zhang, H. The Preharvest Application of Aureobasidium pullulans S2 Remodeled the Microbiome of Tomato Surface and Reduced Postharvest Disease Incidence of Tomato Fruit. Postharvest Biol. Technol. 2022, 194, 112101. [Google Scholar] [CrossRef]
- Muniroh, M.S.; Nusaibah, S.A.; Vadamalai, G.; Siddique, Y. Proficiency of Biocontrol Agents as Plant Growth Promoters and Hydrolytic Enzyme Producers in Ganoderma boninense Infected Oil Palm Seedlings. Curr. Plant Biol. 2019, 20, 100116. [Google Scholar] [CrossRef]
- Chan, Z.; Tian, S. Interaction of antagonistic yeasts against postharvest pathogens of apple fruit and possible mode of action. Postharvest Biol. Technol. 2005, 36, 215–223. [Google Scholar] [CrossRef]

| Yeast | Inhibition (%) | |
|---|---|---|
| Mycelial Growth | Spore Germination | |
| A. pullulans PP4 | 63.05 ± 0.06 a * | 79.66 ± 1.15 a |
| A. pullulans ZD1 | 53.61 ± 0.06 b | 68.97 ± 1.0 b |
Disclaimer/Publisher’s Note: The statements, opinions and data contained in all publications are solely those of the individual author(s) and contributor(s) and not of MDPI and/or the editor(s). MDPI and/or the editor(s) disclaim responsibility for any injury to people or property resulting from any ideas, methods, instructions or products referred to in the content. |
© 2023 by the author. Licensee MDPI, Basel, Switzerland. This article is an open access article distributed under the terms and conditions of the Creative Commons Attribution (CC BY) license (https://creativecommons.org/licenses/by/4.0/).
Share and Cite
Podgórska-Kryszczuk, I. Biological Control of Aspergillus flavus by the Yeast Aureobasidium pullulans In Vitro and on Tomato Fruit. Plants 2023, 12, 236. https://doi.org/10.3390/plants12020236
Podgórska-Kryszczuk I. Biological Control of Aspergillus flavus by the Yeast Aureobasidium pullulans In Vitro and on Tomato Fruit. Plants. 2023; 12(2):236. https://doi.org/10.3390/plants12020236
Chicago/Turabian StylePodgórska-Kryszczuk, Izabela. 2023. "Biological Control of Aspergillus flavus by the Yeast Aureobasidium pullulans In Vitro and on Tomato Fruit" Plants 12, no. 2: 236. https://doi.org/10.3390/plants12020236
APA StylePodgórska-Kryszczuk, I. (2023). Biological Control of Aspergillus flavus by the Yeast Aureobasidium pullulans In Vitro and on Tomato Fruit. Plants, 12(2), 236. https://doi.org/10.3390/plants12020236

